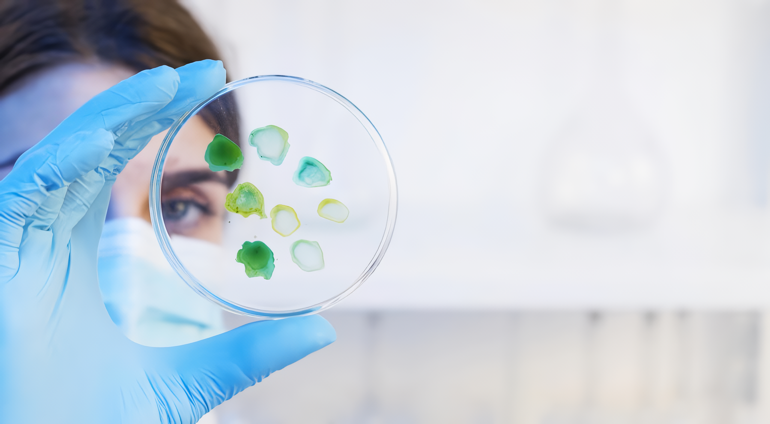

BIOLOGICAL ANALYSIS SERVICES
As SMF Technology, we provide high quality biological analysis services to our customers by using the latest technology and collaborating with accredited biological analysis laboratories. Our biological analyses are tailored to the needs of our customers and optimised to meet specific requirements.